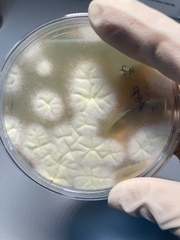
Aspergillus brasiliensis
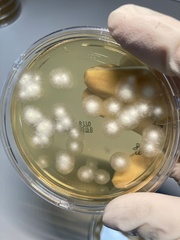
Aspergillus brasiliensis

Aspergillus brasiliensis: taxon details and analytics
- Domain
- Kingdom
- Fungi
- Phylum
- Ascomycota
- Class
- Eurotiomycetes
- Order
- Eurotiales
- Family
- Aspergillaceae
- Genus
- Aspergillus
- Species
- Aspergillus brasiliensis
- Scientific Name
- Aspergillus brasiliensis
Summary description from Wikipedia:
Aspergillus brasiliensis
Aspergillus brasiliensis är en svampart som beskrevs av Varga, Frisvad & Samson 2007. Aspergillus brasiliensis ingår i släktet Aspergillus och familjen Trichocomaceae. Inga underarter finns listade i Catalogue of Life.
...